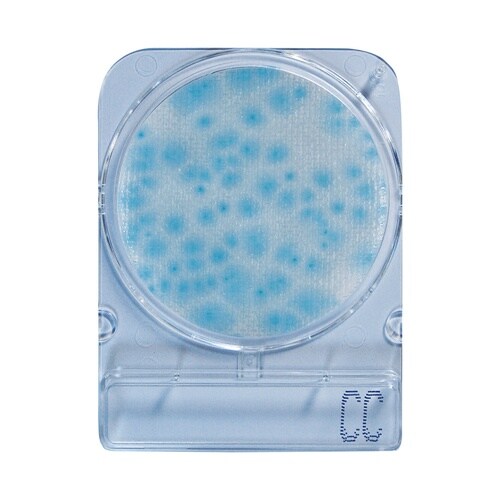
コンパクトドライ(TM) 04299 カ

培地関連用品の売れ筋ランキング
- ¥9,927(税込) (税込) 〜
- ¥11,547(税込) (税込) 〜
- ¥8,162(税込) (税込) 〜
- ¥6,030(税込) (税込)
商品の特徴 |
培地調製の不要な菌数測定用の培地です。接種した試料液は自然に均一に拡散します。発育した集落は着色するため菌数の計測が容易です。発育集落の釣菌が可能です。 |
|---|---|
商品仕様 |
|
メーカー情報 |
|
カタログ掲載ページ |
-/- |
| 注意事項 | ※【お届けに関するご注意】この商品は、画面に表示されているお届け予定日までにお届けいたします。実際のお届けが、予定日よりも早まる場合がございます。 |
|---|